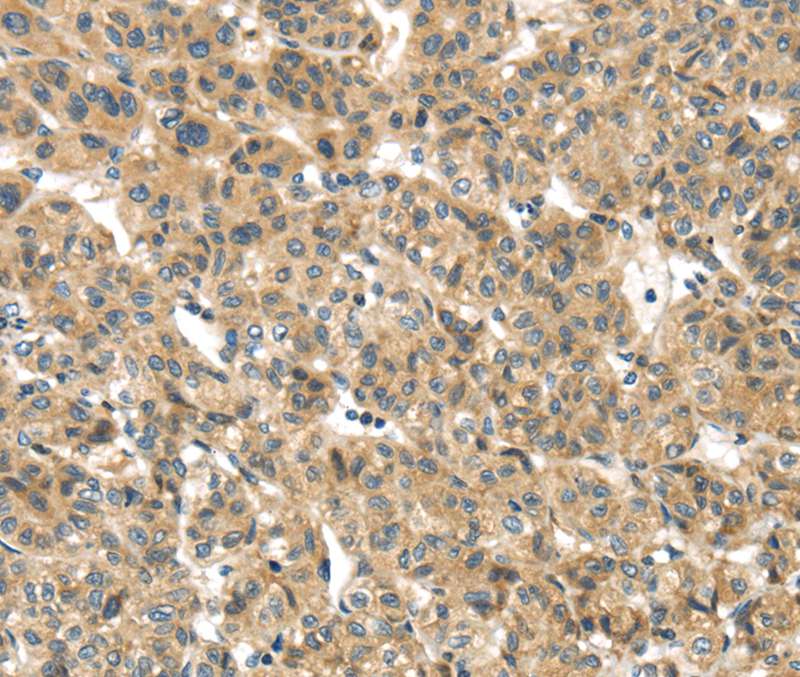
Anti-TMEM161A Antibody

TMEM161A Antibody, Biotin conjugated
CSB-PA023735LD01HU
ApplicationsELISA
Product group Antibodies
ReactivityHuman
TargetTMEM161A
Overview
- SupplierCusabio
- Product NameTMEM161A Antibody, Biotin conjugated
- Delivery Days Customer20
- ApplicationsELISA
- CertificationResearch Use Only
- ClonalityPolyclonal
- ConjugateBiotin
- Gene ID54929
- Target nameTMEM161A
- Target descriptiontransmembrane protein 161A
- Target synonymsAROS-29, AROS29, transmembrane protein 161A, adaptive response to oxidative stress protein 29
- HostRabbit
- IsotypeIgG
- Protein IDQ9NX61
- Protein NameTransmembrane protein 161A
- Scientific DescriptionMay play a role in protection against oxidative stress. Overexpression leads to reduced levels of oxidant-induced DNA damage and apoptosis.
- ReactivityHuman
- Storage Instruction-20°C or -80°C
- UNSPSC41116161